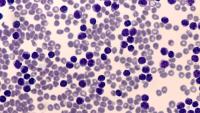

Nicole Lamanna, MD
On the web

Overview
Nicole Lamanna, MD, is an Associate Clinical Professor of Medicine in the Hematologic Malignancies Section of the Hematology/Oncology Division. Dr. Lamanna is a hematologist/oncologist whose research interests include lymphoid leukemias, specifically chronic lymphocytic leukemia.
She is an experienced clinical investigator and her research focus has been the development of combination therapies that include chemoimmunotherapy, immunomodulatory drugs, novel kinase inhibitors and monoclonal antibodies. She also is working to find active, safer therapies for older patients with these diseases.
She earned her medical degree from Albert Einstein College of Medicine and completed her fellowship in Hematology-Oncology at Memorial Sloan-Kettering Cancer Center.
Areas of Expertise / Conditions Treated
- Acute Leukemia
- Acute Lymphocytic Leukemia
- Acute Myelogenous Leukemia
- Acute Myeloid Leukemia
- Chronic Leukemia
- Chronic Lymphocytic Leukemia
- Chronic Lymphoid Leukemia
- Chronic Myelogenous Leukemia
- Essential Thrombocythemia
- Hairy Cell Leukemia
- Hematologic Malignancy
- Hemolytic Anemia
- Immune Thombocytopenic Purpura
- Large Granular Lymphocytic Leukemia
- Myelodysplastic Syndrome
- Myelofibrosis
- Myeloproliferative Disorder
- Polycythemia Vera
- Waldenstrom's Macroglobulinemia
Academic Appointments
- Associate Professor of Medicine at CUMC
Hospital Affiliations
- NewYork-Presbyterian / Columbia University Irving Medical Center
Gender
- Female
Schedule an Appointment
Virtual Visits/Telehealth
Virtual Visits allow you to connect with your provider from the comfort, convenience, and safety of your own home.
Phone Appointments
Connect Patient Portal
For existing patients, login to make an appointment, view documentation or contact your care provider.
Location(s)
Insurance Accepted
Aetna
- Aetna Signature Administrators
- EPO
- HMO
- Medicare Managed Care
- NY Signature
- POS
- PPO
- Student Health
Affinity Health Plan
- Essential Plan
- Medicaid Managed Care
Amida Care
- Special Needs
Cigna
- EPO
- Great West (National)
- HMO
- Medicare Managed Care
- POS
- PPO
Emblem/GHI
- Medicare Managed Care
- PPO
Emblem/HIP
- ConnectiCare
- EPO
- Essential Plan
- HMO
- Medicaid Managed Care
- Medicare Managed Care
- POS
- PPO
- Select Care (Exchange)
- Vytra
Empire Blue Cross/Blue Shield
- EPO
- HMO
- Medicare Managed Care
- PPO
Empire Blue Cross Blue Shield HealthPlus
- Child/Family Health Plus
- Essential Plan
- Medicaid Managed Care
Fidelis Care
- Child/Family Health Plus
- Essential Plan
- Medicaid Managed Care
- Medicare Managed Care
Healthfirst
- Child/Family Health Plus
- Leaf (Exchange)
- Medicaid Managed Care
- Medicare Managed Care
Healthspring (Cigna Medicare)
- Medicare Managed Care
Local 1199
- Local 1199
MagnaCare (National)
- MagnaCare
Medicare
- Railroad
- Traditional Medicare
Multiplan
- Multiplan
MVP Health Care
- Child/Family Health Plus
- Essential Plan
- HMO
- Medicaid Managed Care
RiverSpring
- Special Needs
UnitedHealthcare
- Compass (Exchange)
- Empire Plan
- HMO
- Medicaid (Community Plan)
- Medicare Managed Care
- Oxford Freedom
- Oxford HMO
- Oxford Liberty
- POS
- PPO
VNSNY CHOICE
- Medicare Managed Care
- SelectHealth
- Special Needs
WellCare
- Medicaid Managed Care
- Medicare Managed Care
World Trade Center Health Plan
- World Trade Center Health Plan
Credentials & Experience
Education & Training
- MD, Albert Einstein College Medicine
- Residency: New York University Medical Center
- Fellowship: Memorial Sloan-Kettering Cancer Center
Board Certifications
- Medical Oncology